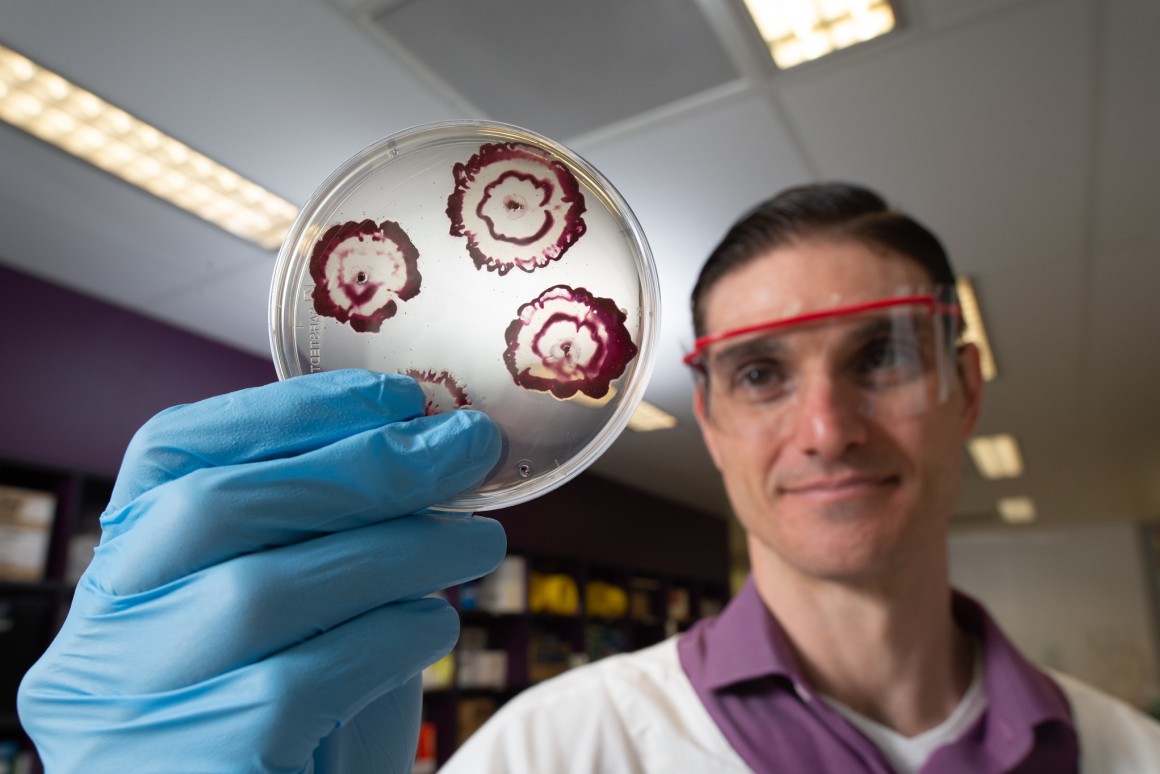

Des chercheurs de la Queensland University of Technology (QUT) ont mis au point des antibiotiques hybrides qui peut perforer certains biofilms. Mais pourquoi avoir inventé ces antibiotiques hybrides ? Les bactéries ne sont pas trop difficiles à tuer. Le problème, c’est qu’elles ont tendance à construire des colonies derrière des barrières appelées biofilms. Ces sont ces barrières qui sont difficiles à pénétrer pour les antibiotiques.
Antibiotiques hybrides et biofilms
Les biofilms posent un problème particulier dans les endroits exposés aux bactéries pendant de longues périodes. Y compris les outils médicaux comme les cathéters ou les implants. Il est donc plus difficile pour les médicaments ou les produits chimiques antibactériens de passer ; et de faire leur travail. Cela entraîne une résistance aux antibiotiques et peut-être des infections récurrentes.
Mais les chercheurs de l’étude actuelle disent qu’ils ont mis au point une nouvelle méthode. « Les biofilms sont un revêtement collant et visqueux qui empêche souvent les antibiotiques conventionnels d’accéder aux cellules bactériennes. », explique Anthony Verderosa, co-auteur principal de l’étude. « Nous avons mis au point une nouvelle race d’antibiotique qui aide les biofilms à libérer leurs cellules protégées en leur permettant d’y accéder par le revêtement visqueux protecteur du biofilm. Cela permet d’éradiquer les biofilms. »
Cette « nouvelle race » est une combinaison d’un antibiotique largement utilisé connu sous le nom de ciprofloxacine, avec des composés appelés nitroxydes. Ces antibiotiques hybrides se sont récemment avérés efficaces pour éliminer les biofilms, laissant la ciprofloxacine entrer et tuer les bactéries.
Test sur des staphylocoques dorés
L’équipe a testé le mélange sur des biofilms faits de staphylocoques dorés (Staphylococcus aureus). On a constaté que les antibiotiques hybrides pénétraient efficacement les biofilms et éradiquaient les bactéries. Mieux encore, qu’il fallait moins de ciprofloxacine que d’habitude pour faire le travail. Ils n’ont vu aucun signe de toxicité pour les cellules humaines saines non plus.
Les chercheurs disent qu’ils se préparent pour les prochains essais chez l’homme. « Ce qui est prometteur, c’est que nos composés sont des hybrides de médicaments qui sont déjà utilisés en clinique comme thérapies autonomes ; comme les antibiotiques et les nitroxydes classiques. Cela laisse espérer qu’ils pourront être transposés en thérapies cliniques dans un avenir pas si lointain « , explique Makrina Totsika, coauteure principale de cette étude.
Parmi les autres méthodes récentes de lutte contre les biofilms, mentionnons l’utilisation d’épurateurs à microbulles pour les éliminer. Le chauffage des nanoparticules pour les détruire, la perturbation des réseaux de communication bactériens de sorte qu’ils ne peuvent se coordonner pour créer des biofilms, ou le développement de revêtements qui sont trop glissants pour que les bactéries s’y établissent.